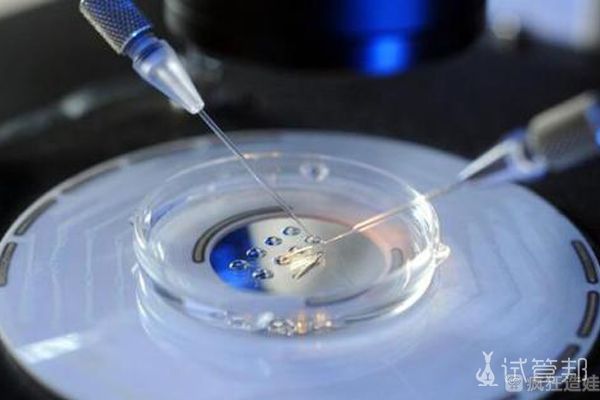

选择厦门大学附属第一医院做第二代试管婴儿顺利好孕
- 试管婴儿
- 2025-09-10 10:27
我患有子宫腺肌症,肌瘤足足有3.5cm大,因为这个疾病,每次来姨妈的时候都痛不欲生,整个人就是在地上打滚。去医院检查说有个小肌瘤,后面结婚2年都没有过一次怀孕经历,婆婆很是着急,让我们去医院检查,最好是直接做二代试管婴儿省事,而且婆婆还说到时生了孩子痛经就会消失的。于是,我跟老公开始去到厦门大学附属第一医院检查,跟医生说想做二代试管婴儿,正式开启试管之路。医生的态度都挺和蔼的,从前期的检查定方案,到后期的促排取卵,再到胚胎移植,短短的2个月时间里,我感受到了专业耐心的服务。
在厦门大学附属第一医院检查到促排都很顺利,差不多花了一个多月的时间,促排期间,按照嘱咐,准时打针或者复查。刚开始是打了有三四天的针,回去复查,泡泡长得有点慢,调整了药物和剂量,差不多打了10天的针,等到了收针。打完夜针隔了36个小时就取卵了,取卵前特别紧张,老公怕我疼想要求全麻,但我担心影响卵子质量,选择了局麻。还好手术时间短,也不是一直都有刺痛感,结束后知道取了只有6个卵子。二代试管婴儿胚胎移植真的特别快,也不痛,老公坚持接送我,希望把我和宝宝一起接回家,胚胎移植完心情异常的轻松。
老天爷会眷顾努力的我们,第8天我测到了两条杠,不明显但已经有印记了,随着时间增长,颜色也越来越深,如我们期望的那般,14天去抽血开奖成功。现在确定肚子里是一个崽崽,只希望他健康希望我的经历可以给到你们鼓励,加油哦~
相比于同龄去做二代试管婴儿的姐妹们来说,我算是非常幸运的了, 20年在疫情爆发后,幸运的我竟然在厦门市妇幼保健院二代试管婴儿一次成功了,终于拥有了我的小公子。记得我刚验孕成功的时候,真是是无比的激动、感恩,好多姐妹有私信问哪里做的,安全吗?其实我想说,二代试管婴儿技术毕竟是医疗范畴,我做之前就知道不是百分百成功的,如果谁和你说一定成功这种“鬼话”去,千万别信。
二代试管婴儿之所以能一次成功率,除了个人自身身体状况良好以外,再则就是选择的医院医生技术如何这一块了。我想说的是一定要选择一个有资质的医院,不要过分的去贪图便宜,也别因为心急上当,最后伤害的只有自己。我也是在朋友的极力推荐下,我们去了厦门市妇幼保健院,无论是资质背景还是医疗水平都很强大。而且因为我了解到有一个之前深受不孕不育困扰了多年的患者就是在厦门市妇幼保健院做的二代试管婴儿成功怀上的孩子,有这样一个成功案例在身边自然更加有信心了。医生护士的态度也是真的很好,全程都是很耐心的叮嘱我一些注意事项,反正全程遵医嘱就好了。
整个过程说完全没有疼痛不适感那肯定是假的,但也没有网上一些人说的那么可怕,我觉得也就取卵后肚子会有点酸痛,但是可以喝冬瓜汤,还是挺管用的。现在我也是二代试管婴儿成功接好孕了,建议没怀起的朋友可以放下心中的担忧,准备好了就去试试哦。

发表评论